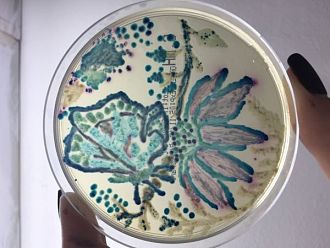
Студенти от МУ-Пловдив създадоха рисунки от бактерии и гъбички

Уникални рисунки от живи бактерии, дрожди и гъбички създадоха студенти от Медицински университет – Пловдив, съобщиха от учебното заведение. 32 бъдещи медици приеха предизвикателството на Катедрата по микробиология и имунология и се включиха в националния конкурс Агар арт във връзка с Европейския ден за разумна употреба на антибиотиците, който гостува във висшето училище под тепетата. Така чрез необичайната форма на изкуство младите хора показаха, че бактериите имат и редица полезни свойства и понякога могат да бъдат и невероятен източник на емоции.
Студент по медицина, артистичен зъб, бебе, паник атака, пролет, красива пеперуда и пътуване в Космоса са само малка част от нестандартните творби на пловдивските „художници". Победител в конкурса тази година е първокурсничката Анастасия Николова и нейният „Платон". Втора награда получиха Елиф Халил с „Пеперуда" и Ким Зимерман с „Queen cat", а трета – третокурсничката Даниела Миланова с „Caput medusa".
"Завършила съм Художествена гимназия и като цяло рисуването ми е в кръвта", призна Анастасия Николова, за която се оказало истинско предизвикателство да експериментира с нов материал като гъбички и бактерии.
Бъдещият лекар призовава също за разумна употреба на антибиотиците. "Много хора си мислят, че всяка настинка може да се лекува с антибиотик, което не е вярно. И същевременно злоупотребяват с тях", казва Анастасия.
„Тази година броят на студентите, които участваха в конкурса в нашия университет е удвоен в сравнение с миналата година.", съобщи ректорът на МУ-Пловдив проф. д-р Мариана Мурджева.
В България началото на този тип рисунки е поставено през 2016 година, когато списание „Българска наука" и Ридаком организират конкурс „Агар Арт" по аналог на Agar Art Contest на Американското общество по микробиология. Той е вдъхновен от първата в света рисунка с микроорганизми на българския микробиолог Росица Ташкова - бактериална елхичка, която предизвиква невероятен интерес.
Създава я, докато пише дипломната си работа за магистър в университета на Нант. Тогава Роси решава да направи нещо нестандартно, с което да зарадва колегите, а и себе си. Идеята й хрумва, докато разчиства вече непотребни петрита с хранителни среди и пораснали по тях разноцветни микроби. Така бактериите се превръщат в палитра. След като елхичката на Росица пораства, тя качва нейна снимка в сайта на Американското дружество по микробиология и за кратко време става най-харесваният, коментиран и споделян пост във Фейсбук страницата на организацията. След няколко месеца те обявяват и първия в света конкурс за рисунка с микроорганизми върху хранителна среда.
Първото издание на конкурса предизвиква огромен интерес и в България. Още на следващата година екипи от микробиолози от цялата страна се впускат в предизвикателството да покажат своите умения в майсторенето на произведения от различни бактерии.
Коментари по темата
потърсете в Youyube Selling painting made of shit | Who is America